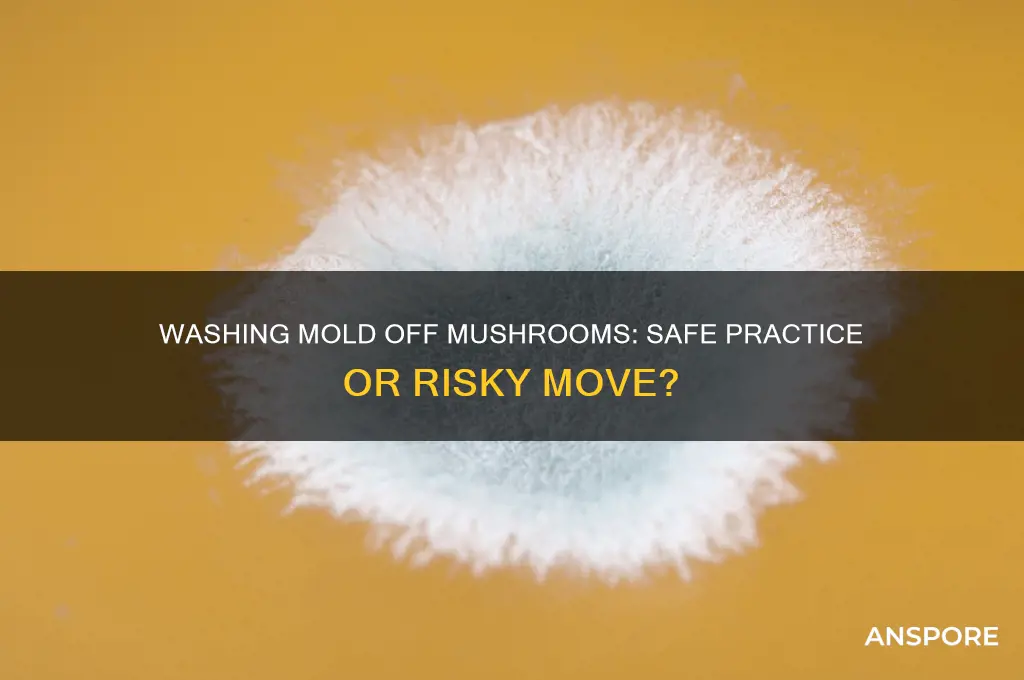
can i wash mold off mushrooms

When encountering mold on mushrooms, it’s natural to wonder if washing it off can salvage them. However, mold on mushrooms is a clear sign of spoilage, as it indicates the presence of harmful microorganisms that can penetrate the mushroom’s porous surface. Washing moldy mushrooms does not effectively remove the toxins produced by the mold, and consuming them can pose health risks, including allergic reactions or foodborne illnesses. It’s best to discard moldy mushrooms entirely to avoid potential contamination and ensure food safety. Always inspect mushrooms carefully before use and store them properly to prevent mold growth.
| Characteristics | Values |
|---|---|
| Can Mold Be Washed Off Mushrooms? | No, it is not recommended to wash mold off mushrooms. Mold can penetrate the mushroom's surface, making it unsafe to consume even after washing. |
| Safety Concerns | Mold on mushrooms produces mycotoxins, which are harmful and can cause food poisoning or allergic reactions. |
| Visible Mold | If mold is visible, the mushroom should be discarded entirely, as the mold can spread internally. |
| Prevention Tips | Store mushrooms in a paper bag in the refrigerator to maintain freshness and reduce moisture buildup. |
| Alternative Uses | Moldy mushrooms should not be used in cooking, composting, or feeding pets due to health risks. |
| Expert Advice | Food safety authorities (e.g., USDA) advise against consuming moldy mushrooms, even if mold appears superficial. |
| Shelf Life | Fresh mushrooms typically last 5-7 days in the fridge; inspect regularly for signs of mold. |
Explore related products
What You'll Learn

Effectiveness of Washing Mold
Washing mold off mushrooms seems like a quick fix, but its effectiveness hinges on the type of mold and the mushroom’s structure. Surface molds, such as those on button or cremini mushrooms, may partially wash away under cold water. However, mold penetrates porous surfaces, and mushrooms, with their spongy texture, often absorb mold spores internally. Rinsing might remove visible mold but fails to eliminate microscopic spores or mycotoxins, which can cause health issues like allergic reactions or gastrointestinal distress. For this reason, experts generally advise against consuming moldy mushrooms, even after washing.
Consider the washing process itself: gently rinse the mushrooms under cold water, avoiding vigorous scrubbing that could damage their delicate flesh. While this method might suffice for minor surface mold, it’s a gamble. Mold spores are resilient and can survive washing, especially in deeper crevices. A more thorough approach involves trimming affected areas and washing, but this still doesn’t guarantee safety. The risk lies in the invisible toxins produced by mold, which washing cannot remove. Thus, the effectiveness of washing is limited and unreliable for ensuring safety.
From a comparative standpoint, washing mold off hard-surfaced foods like carrots or apples is more effective because their dense structure prevents deep penetration. Mushrooms, however, are a different case. Their porous nature allows mold to infiltrate quickly, rendering washing insufficient. For instance, a study on mold remediation found that while washing reduced surface mold by 70% on firm vegetables, it only achieved a 30% reduction on mushrooms. This disparity underscores the ineffectiveness of washing as a solution for moldy mushrooms.
Practically speaking, prevention is far more effective than remediation. Store mushrooms in paper bags in the refrigerator to maintain airflow and reduce moisture, which discourages mold growth. If mold appears, discard the affected mushrooms and inspect nearby produce, as mold spores spread easily. While washing might seem like a solution, it’s a temporary and risky fix. The safest approach is to err on the side of caution and avoid consuming moldy mushrooms altogether.
Mushrooms and Sleep: Unraveling the Insomnia Connection
You may want to see also

Safety Risks of Consuming Moldy Mushrooms
Mold on mushrooms is not merely a surface issue; it signals deeper contamination. Unlike firm vegetables, mushrooms’ porous structure allows mold to penetrate quickly, making it impossible to remove all toxins by washing or cutting. Even if visible mold is scrubbed off, mycotoxins—toxic compounds produced by mold—remain embedded, posing serious health risks. This hidden danger is why experts universally advise against consuming moldy mushrooms, regardless of cleaning efforts.
The risks of ingesting moldy mushrooms extend beyond mild discomfort. Mycotoxins can cause acute symptoms such as nausea, vomiting, and diarrhea, particularly in sensitive individuals like children, the elderly, or those with compromised immune systems. Aflatoxins and ochratoxin A, common mold-produced toxins, are linked to liver damage and kidney dysfunction, respectively. Chronic exposure, even in small amounts, may increase the risk of long-term health issues, including organ toxicity and potential carcinogenic effects.
Comparing mushrooms to other moldy foods highlights their unique vulnerability. Hard cheeses, for instance, can often be salvaged by cutting away moldy parts because their dense structure limits toxin spread. Mushrooms, however, lack this protective barrier. Their high moisture content and soft texture create an ideal environment for mold to thrive and disperse toxins rapidly. This distinction underscores why the “cut and keep” approach, safe for some foods, is unsafe for mushrooms.
To avoid these risks, prioritize prevention. Store mushrooms properly by keeping them in paper bags in the refrigerator to maintain airflow and absorb excess moisture. Use them within a week of purchase, as mold growth accelerates with age. If mold is detected, discard the entire batch, as spores can spread invisibly to unaffected areas. While composting is an eco-friendly disposal method, ensure moldy mushrooms are sealed in a bag to prevent spore dissemination in your garden.
In summary, the safety risks of consuming moldy mushrooms far outweigh the effort to salvage them. Washing or trimming cannot eliminate embedded mycotoxins, leaving you vulnerable to acute and chronic health issues. By understanding mushrooms’ unique susceptibility to mold and adopting proper storage practices, you can protect yourself and your family from unnecessary dangers. When in doubt, throw it out—it’s a small price to pay for peace of mind.
Boiling Enoki Mushrooms: Tips, Benefits, and Delicious Recipe Ideas
You may want to see also

Proper Cleaning Techniques for Mushrooms
Mushrooms, with their porous surfaces, absorb water like sponges, making them prone to mold if not handled correctly. While a small amount of mold on mushrooms might seem harmless, it’s a sign of decay and can produce mycotoxins, which are harmful if ingested. The question of whether you can wash mold off mushrooms is nuanced: while washing can remove surface mold, it doesn’t eliminate toxins that may have penetrated deeper tissues. Therefore, the safest approach is to discard visibly moldy mushrooms entirely. However, for mushrooms without mold, proper cleaning techniques are essential to preserve their texture and flavor while ensuring safety.
The first step in cleaning mushrooms is to avoid soaking them in water. Their absorbent nature means prolonged exposure to water can make them soggy and dilute their earthy flavor. Instead, use a quick rinse under cold running water, gently rubbing the caps and stems with your fingers or a soft brush to dislodge dirt. For particularly dirty mushrooms, such as wild varieties, use a damp paper towel or cloth to wipe away debris. The goal is to minimize water contact while effectively removing surface impurities.
A lesser-known but effective technique is dry brushing. This method is ideal for delicate varieties like chanterelles or shiitakes, which can be damaged by water. Use a mushroom brush or a clean pastry brush to sweep away dirt and debris. Dry brushing not only preserves the mushroom’s texture but also maintains its concentrated flavor. After brushing, a quick wipe with a damp cloth can address any remaining particles without saturating the mushroom.
For those who prefer a deeper clean, a vinegar bath can be a useful tool. Mix one part white vinegar with three parts water, and briefly dip the mushrooms into the solution for 10–15 seconds. The acidity of the vinegar helps kill bacteria and remove pesticides, though this method should be followed by a thorough rinse to avoid a lingering vinegar taste. This technique is particularly beneficial for store-bought mushrooms, which may have been exposed to chemicals during cultivation.
Finally, proper drying is crucial after cleaning. Excess moisture can accelerate spoilage and affect cooking results. Pat mushrooms dry with a clean kitchen towel or paper towels, or let them air-dry on a rack for a few minutes. If time is a constraint, a salad spinner can be used to gently remove water without damaging the mushrooms. Cleaned and dried mushrooms should be stored in a paper bag or loosely wrapped in a towel in the refrigerator, where they’ll stay fresh for up to a week. By mastering these techniques, you can ensure your mushrooms are safe, flavorful, and ready for any culinary creation.
Are Morel Mushrooms Poisonous? Unraveling the Truth About Toxicity
You may want to see also
Explore related products

Signs of Spoilage Beyond Mold
Mushrooms, like all fresh produce, have a limited shelf life, and mold is just one indicator of spoilage. While visible mold growth is a clear sign to discard them, other less obvious signs can signal that your mushrooms are past their prime. Understanding these signs is crucial for food safety and culinary quality.
Texture Changes: Fresh mushrooms should have a firm, slightly spongy texture. If they become slimy or excessively soft, it’s a red flag. This sliminess is often caused by bacterial growth or enzymatic breakdown, neither of which is reversible by washing. For example, if the gills of a button mushroom feel sticky or the cap collapses under gentle pressure, it’s time to toss them.
Color Alterations: While mushrooms naturally darken slightly as they age, significant discoloration is a warning sign. A healthy mushroom should maintain its original hue, whether white, brown, or cream. If you notice black or green spots (unrelated to mold) or an overall dull, grayish appearance, these changes indicate spoilage. This is particularly true for shiitake or oyster mushrooms, which can develop off-colors more rapidly.
Odor: Fresh mushrooms have a mild, earthy aroma. If they emit a sharp, ammonia-like smell or a sour odor, it’s a sign of bacterial activity. This is especially noticeable in closed containers, where gases produced by spoilage can accumulate. Trust your nose—if the smell is off, the mushrooms are likely unsafe to eat.
Leakage and Shrinkage: As mushrooms age, they may start to release liquid, a process known as "weeping." This is a natural defense mechanism but also accelerates spoilage. Conversely, severe shrinkage can occur as mushrooms lose moisture, making them dry and tough. Both conditions compromise texture and flavor, rendering them unsuitable for cooking.
Practical Tips: To extend mushroom freshness, store them in a paper bag in the refrigerator, which allows air circulation while absorbing excess moisture. Avoid washing until ready to use, as excess water accelerates decay. If you notice any of the above signs, discard the mushrooms immediately, even if only a portion appears affected. When in doubt, remember: it’s better to be safe than sorry.
Steaming Enoki Mushrooms: A Quick and Healthy Cooking Guide
You may want to see also

Preventing Mold Growth on Stored Mushrooms
Mold on mushrooms is a common issue, but washing it off isn’t a reliable solution. Spores can penetrate the surface, rendering the mushroom unsafe to eat even after cleaning. Prevention is the better strategy. Start by storing mushrooms properly to inhibit mold growth. Keep them in their original packaging or a paper bag in the refrigerator, as these materials allow airflow while absorbing excess moisture. Avoid airtight containers or plastic bags, which trap humidity and accelerate spoilage.
Temperature and humidity control are critical. Mushrooms thrive in cool, dry environments, so store them in the main compartment of the refrigerator, not the crisper drawer, where humidity levels are higher. Aim for a fridge temperature of 38–40°F (3–4°C). If your refrigerator has a humidity-controlled drawer, set it to low humidity for mushroom storage. For longer-term preservation, consider drying or freezing mushrooms. Drying removes moisture entirely, while freezing halts mold growth, though texture may change slightly upon thawing.
Another preventive measure is to inspect mushrooms before storage. Discard any with visible damage, bruising, or early signs of mold, as these can spread quickly. If you buy in bulk, divide mushrooms into smaller portions to reduce handling and exposure to air. For pre-washed mushrooms, pat them dry with a paper towel before storing to minimize residual moisture.
Finally, consider the role of ethylene gas, a natural plant hormone that accelerates ripening and spoilage. Mushrooms are sensitive to ethylene, so store them away from ethylene-producing foods like apples, bananas, and tomatoes. This simple separation can extend their shelf life by several days. By combining these strategies, you can significantly reduce the risk of mold growth and enjoy fresher mushrooms for longer.
Lion's Mane Mushroom Overdose: Risks, Safety, and Proper Dosage Explained
You may want to see also
Frequently asked questions
No, you should not eat mushrooms with mold. Even if you wash it off, mold can penetrate the mushroom, making it unsafe to consume.
If only a small portion of the mushroom has mold, you can trim that part and the surrounding area thoroughly. However, if the mold is widespread, discard the entire mushroom.
Washing mold off mushrooms does not eliminate the risk, as mold spores can spread and toxins may already be present. It’s best to discard moldy mushrooms to avoid potential health issues.

























